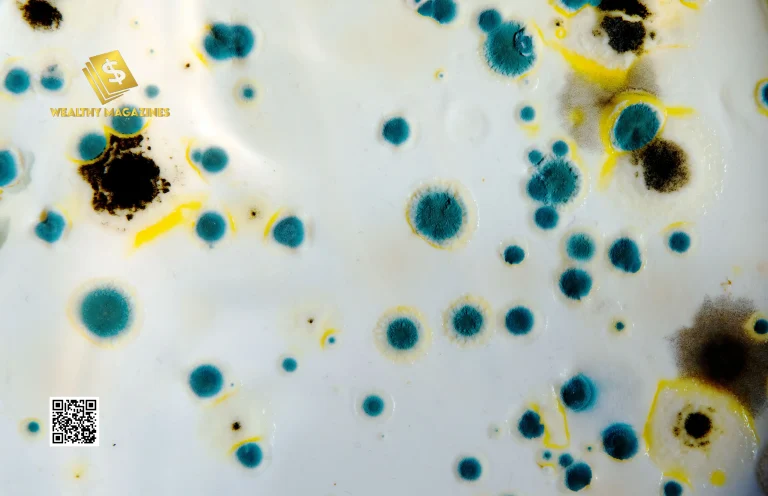
10 Warning Signs of Mold Toxicity That You Should Know

You may already know that mold is ubiquitous, but you’ll be surprised to learn that it can be dangerous when it’s inside your home but not when it’s outside. Yes, you heard that right. Not only does mold have an unpleasant smell, but frequent exposure to it inside a building can be detrimental to your health.
Mold is the most common type of fungus, and when it settles and grows in damp areas in workplaces or homes, it usually poses a risk to human health.
When mold enters our body, it causes a number of health issues. While not all mold is toxic to humans, some of it produces chemicals known as mycotoxins that are very bad for human health. Therefore, breathing in or consuming mold spores is what causes mold toxicity.
Additionally, diagnosing and treating mold toxicity is quite complicated, so it is important to be aware of the warning signs.
That’s why we’ve included 10 warning signs of mold toxicity in this article to assist you in gaining a better understanding of the initial symptoms of this toxicity and seeking appropriate treatment.
List of the 10 warning signs of mold toxicity:
When mold toxicity is present, people frequently confuse its symptoms and early warning signs with those of other disorders. If, on the other hand, you are facing more than one of these issues, mold may be the cause. The 10 warning signs of mold toxicity are:
- Allergies
- Headaches and brain fog
- Weakness and fatigue
- Respiratory problems or asthma
- Depression and mood swings
- Digestive problems: diarrhea, nausea, and abdominal pain
- Cognitive issues
- Joint pain or muscle cramps
- Skin problem
- The immune system compromises
Let’s look at each one of these symptoms in more detail.
Allergies:

The first one of the 10 signs of mold toxicity is an allergic reaction which indicates that there may be a mold problem. Many people who are exposed to mold develop mold allergies. As a result, individuals may exhibit symptoms similar to those listed below:
- Nasal congestion
- Breathing difficulty
- Swollen eyes
- Coughing and sneezing
- Irritated lung,
- Sore throat
- Headaches
Usually, an allergic reaction to mold is temporary and disappears as soon as you eliminate the allergen or remove yourself from the environment. However, if you are unable to escape the environment or mold exposure is inevitable, you may be more vulnerable to subsequent issues and an increased immune response.
Headache and Brain Fog:
According to a study in 2019, headaches are the most common among the 10 warning signs of mold toxicity. Headaches may result from mold, particularly if you are prone to spore sensitivity. These headaches may come on frequently, be very intense, and turn into migraines.
Mold toxicity can result in persistent headaches and cognitive issues like lack of focus and improper thinking, also known as brain fog.
As a result, a continuous haze around your thoughts makes it hard to think clearly, which is one of the disturbing symptoms linked to mold toxicity.
Weakness and Fatigue:

Similar to other cognitive changes, almost all people who are exposed to mold experience weakness and fatigue. This exhaustion is mostly unexplainable and sometimes associated with trouble sleeping, while other times it is completely independent of the quality or amount of sleep. For instance, people can have consistent 8 to 9 hours of sleep and yet feel tired.
Respiratory Problems or Asthma:
Respiratory problems are the most common form of mold toxicity among the 10 warning signs of mold toxicity. Mold spores, when inhaled, cause respiratory tract inflammation, resulting in asthma and other respiratory disorders. Possible symptoms may include coughing, wheezing, shortness of breath, and tightening of the chest.
Depression and Mood Swings:
Your mood may also be affected by mold exposure. You might have irritability, anxiety, or depression. If you have a history of mental health issues, these symptoms can be more severe.
Digestive Problems: Diarrhea, Nausea, and Abdominal Pain:
Among the 10 warning signs of mold toxicity, food intolerance issues and other digestive disorders like bloating, gas, and constipation are common in people with mold toxicity.
Mold toxicity has also been linked to gastrointestinal issues like nausea, diarrhea, and abdominal pain. Your digestive system may suffer greatly from mycotoxins, which can cause these unpleasant symptoms.
Cognitive Issues:
One of the most dangerous of the 10 warning signs of mold toxicity is cognitive impairment, which includes memory loss and concentration issues. Brain fog can occur, which makes it difficult to concentrate and finish tasks quickly.
Joint Pain or Muscle Cramps:
Mold poisoning also affects the skeletal muscle system. If you experience general discomfort, cramping in your muscles, or unexplained joint pain, mold exposure may be a factor. Finding and treating the underlying cause of any pain is crucial, but joint discomfort in particular can be quite crippling.
Skin Problem:

The next one of the 10 warning signs of mold toxicity is frequently evident by the appearance of skin symptoms such as rashes, hives, and itching. When the body reacts to the poisonous mold spores that are present in the environment, these skin problems become apparent.
The Immune System Compromise:
The toxic effects of mold can have a negative impact on your immune system, making you more susceptible to contracting illnesses. If you notice that you are frequently sick or have difficulty recovering from common illnesses, it is possible that mold is weakening your immune responses.
How do you know if you are exposed to mold or have mold toxicity?
You might find these 10 warning signs of mold toxicity confusing because many of them, like fatigue, headaches, mood swings, and depression, could be the result of another medical condition.
It’s hard to tell if someone is sick from mold because the sickness doesn’t usually follow a pattern and doesn’t have a specific sign that only mold toxicity causes. Also, there isn’t a clear-cut way to tell if something is mold-related or not; instead, you have to rule out other possibilities.
Mold can grow inside for many reasons, such as water leaks, air conditioners, high humidity, and other damp places. If you experience any of those 10 warning signs of mold toxicity it is suspected that mold is present somewhere around your house, one of the first things you can do is have your home checked. You can ask your doctor or nurse for a list of people they think you should call for an at-home mold test.
How long does it take for mold to leave your system?
When ingested or inhaled, mold can pose health risks. The amount of time it takes for mold to leave your body varies depending on your immune system, overall health, and the type and amount of mold exposure.
Preventing Mold Toxicity:
Mold grows in damp areas; therefore, regulating the humidity in your home and office is key to preventing mold poisoning. These methods lower the likelihood of mold growth; however, mold spores are naturally present in most situations. Mold prevention is the best strategy to avoid mold spores. Here are some preventive measures to protect your house from mold:
- Keep Home Dry
- Find and fix leaks.
- Make sure the home has enough air circulation.
- Immediately dry wet areas
Treatment:
If you are diagnosed with this toxicity, it is best to avoid any potential risks. Reducing your exposure to mold is the best course of action. Here are some ways you can treat this illness:
Enhance Indoor:
Air Quality: Air filters minimize mold spores and enhance indoor air quality.
Medication:
For mold toxicity symptoms, doctors may prescribe antihistamines for allergies and nasal corticosteroids for respiratory issues.
Toxin removal:
You can use detoxification treatments. This may include drinking water, taking nutrients, or detoxifying.
Nutritional Support:
Supplements and a healthy diet may improve mold toxicity recovery.
Overall, mold exposure can occur at any point in our lives. Therefore, having a good understanding of the list of 10 warning signs of mold toxicity will help us avoid further exposure and get treatment in time.
For more info visit Wealthymagazines.com